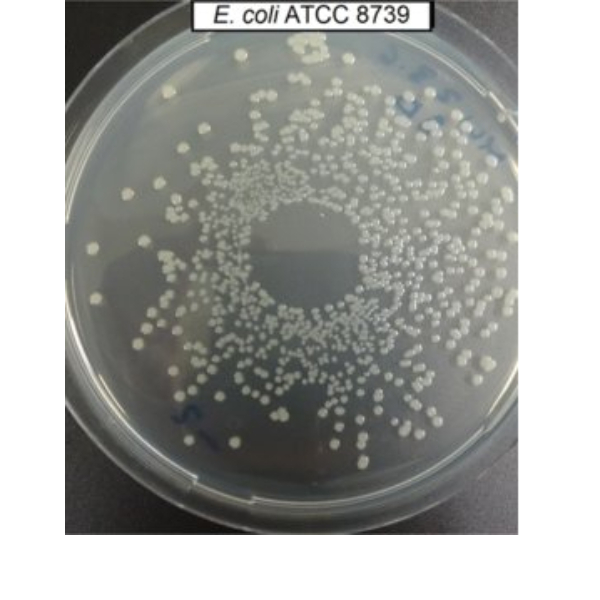
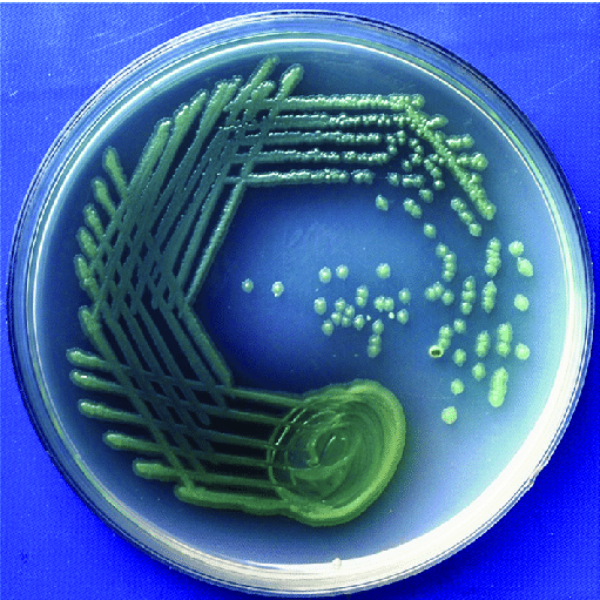

سوش باکتریایی چیست؟
باکتری ها به دلیل ساختار ژنتیکی خود انواع مختلفی دارند. گاهی این اختلاف به حدی است که می توان دو باکتری را با 30% اختلاف ژنتوتیپی(ژنتیکی) دو گونه جدا از هم نامید. زمانی که این اختلاف ژنتیکی به کمتر از 12% کاهش یابد دو باکتری متعلق به یک گونه می باشد که به آن سوش باکتری می گویند. به بیان دیگر سوش میکروبی(strian) به یاخته های بدست آمده از یک کشت خالص را می گویند که از نظر ژنتیکی تنها 12% با هم تفاوت دارند.
سوش استاندارد باکتری
تفاوت در ژنتیک باکتری باعث به وجود آمدن انواع مختلفی از گونه و سوش باکتریایی شده است به همین دلیل هر سوش باکتری که کشف شود یک شناسنامه برای آن تشکیل می شود. در این شناسنامه اطلاعات ژنتیکی، شکل ظاهری، فرد کاشف و زمان کشف در آن ذکر می گردد که از این طریق استاندارد بودن یک سوش باکتری را می توان متوجه شد. هر کشوری دارای ذخایر ژنتیکی است که در بخشی از این ذخایر اطلاعات سوش های باکتری که برای اولین بار در آن کشور به ثبت رسیده و یا خاستگاه اصلی آن سویه هستند را شامل می شود.
بزرگ ترین و جامع ترین بانک اطلاعات زیستی دنیا در آمریکا واقع شده است که تمامی سوش ها با کد ATCC نام گذاری شده اند شناخته می شود. از دیگر کدگذاری های انجام شده روی سوش های باکتری DSM است که مربوط به بانک زیستی کشور آلمان می باشد. کدگذاری سوش های باکتری به این صورت است که پس از نام باکتری یک کد اختصاصی همراه با عدد قرار می گیرد. این اعداد اختصاصی بوده و برای هر سوش باکتری یک کد اختصاص داده می شود.
باکتری لیوفیلیزه
سوش های باکتری را اغلب به صورت لیوفیلیزه نگهداری می کنند. لیوفیلیزه کردن یکی از روش های نگهداری باکتری است که بااستفاده از این روش می توان باکتری را برای مدت زمان طولانی تری نگهداری کرد.
روش لیوفیلیزه کردن
لیوفیلیزه کردن و یا خشک کردن انجمادی از جمله راه های نگهداری طولانی مدت ماده های زیستی و دارویی و مواد غذایی است. اساس کار لیوفیلیزه به این صورت است که ماده ابتدا منجمد شده سپس آب درون آن به روش تصعید خارج می شود. با این روش می توان باکتری ها، قارچ ها، اسید های نوکلئیک، پروتئین و دیگر مولکول های زیستی برای مدت طولانی نگهداری کرد.
نکات استفاده از باکتری لیوفیلیزه
- پس از دریافت نمونه لیوفیلزه سوش باکتری حتما نام و مشخصات درج شده روی ویال را با سفارش خود بررسی نمایید
- شرایط نگهداری از ویال لیوفیلیزه، نکات ایمنی و محیط کشت مناسب برای میکروارگانیسم را مطالعه نمایید
- تمامی نمونه ها یک بار مصرف بوده و پس از باز شدن درب آن باید سریعا در محیط کشت مناسب کشت داده شود
مراحل تهیه سوش باکتری
- ابتدا درپوش پلاستیکی نمونه را با الکل ضدعفونی کرده و اجازه دهید تا کاملا خشک شود
- سپس مقداری از نمونه محیط کشت مایع ذکر شده در برگه آنالیز را روی باکتری لیوفیلیزه ریخته و با کمک تکان دادن نمونه را حل می کنیم
- در انتها مقدار 100 تا 200 میکرولیتر از سوسپانسیون بدست آمده را بر روی پلیت محیط کشت غیر اختصاصی ذکر شده در برگه آنالیز منتقل کرده و به مدت 24 تا 48 ساعت در دما مناسب انکوبه نمایید